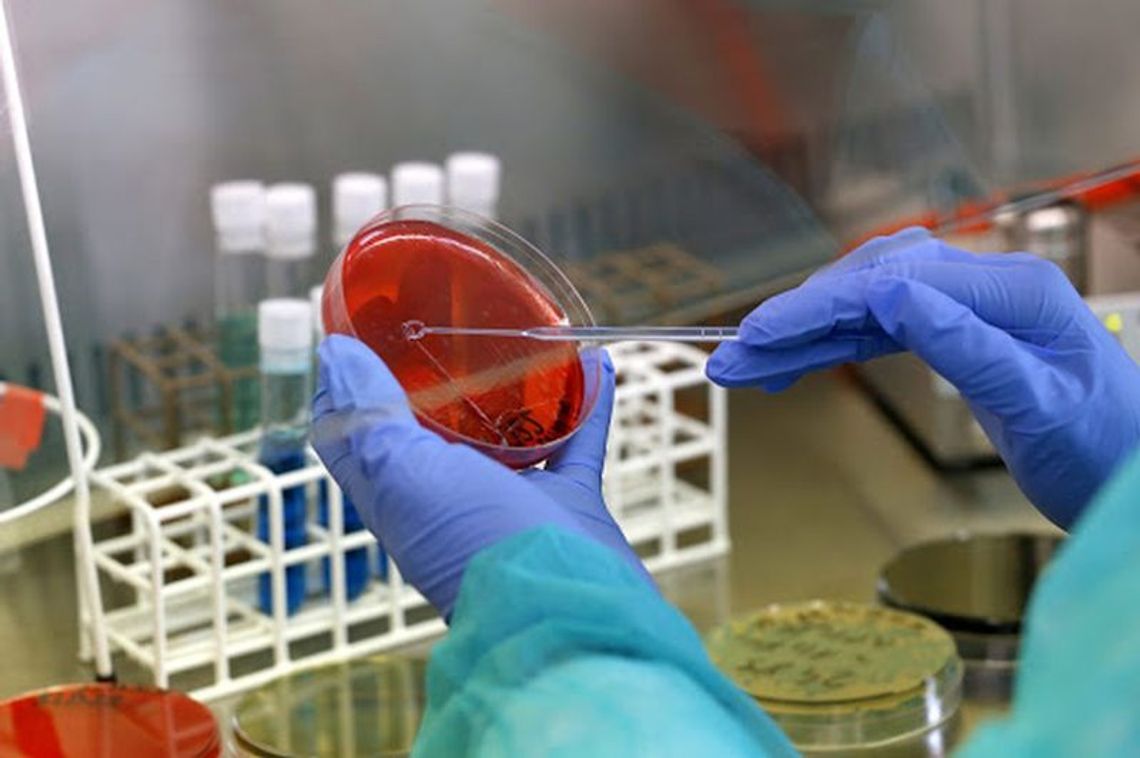
Wynik badania na koronawirusa negatywny Wynik badania na koronawirusa negatywny

Przypomnijmy, w niedzielę Państwowy Powiatowy Inspektor Sanitarny w Gryfinie otrzymał informację od lekarza w Chojnie o wystąpieniu objawów chorobowych u osoby, która wróciła z ternu Niemiec. Podjęto decyzję o przewiezieniu pacjentki do szpitala w Szczecinie.
Mieszkanka Chojny pracowała w Niemczech, opiekując się osobami starszymi. Po powrocie do Polski źle się poczuła, miała objawy grypowe.
O sprawie pisaliśmy wcześniej tutaj:

Napisz komentarz
Komentarze